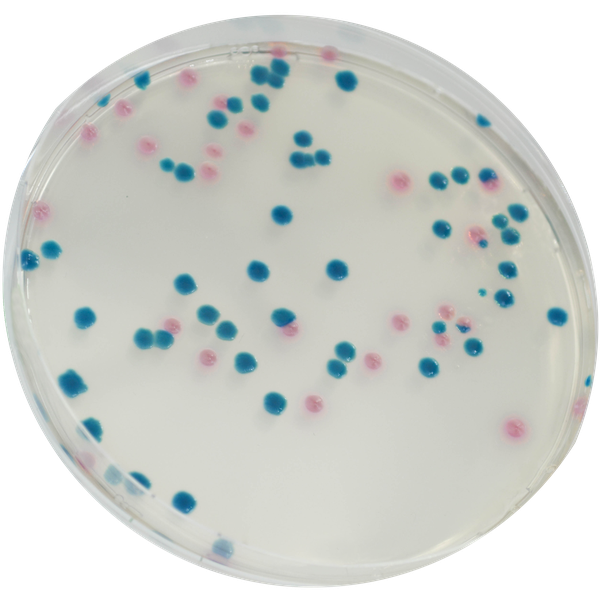
CHROMagar™ mSuperCARBA™

Hình thái khuẩn lạc

CPE E. coli
hồng đậm đến đỏ

CPE Klebsiella, Enterobacter, Citrobacter
xanh kim loại

CPO Pseudomonas
kem trong suốt đến xanh

CPO Acinetobacter
kem, đục
Hiệu năng
Hiệu năng
CDC: «Các Enterobacteriaceae kháng carbapenem (CRE) thường kháng lại tất cả các tác nhân β-lactam cũng như hầu hết các lớp tác nhân kháng khuẩn khác. Các lựa chọn điều trị cho bệnh nhân bị nhiễm CRE là rất hạn chế. Các đợt bùng phát CRE liên quan đến y tế đã được báo cáo. Bệnh nhân mang CRE được cho là nguồn truyền nhiễm trong môi trường y tế. Xác định bệnh nhân mang CRE và đặt các bệnh nhân này vào phòng cách ly có thể là một bước quan trọng để ngăn chặn lây truyền».
CHROMagar™ ra mắt vào năm 2007 với môi trường chromogen đầu tiên để phát hiện vi khuẩn kháng carbapenem, đặc biệt nhắm vào enzyme KPC. Kể từ đó, nhiều loại carbapenemase khác đã lan rộng khắp thế giới và do đó cần phải giải quyết việc phát hiện khó khăn các carbapenemase ở mức độ thấp ngày nay.
Alain Rambach và Patrice Nordmann đã kết hợp nỗ lực để phát triển môi trường chromogen có độ nhạy cao, CHROMagar™ mSuperCARBA™, thế hệ mới của môi trường chromogen đạt hiệu năng chưa từng có: phát hiện được nhiều loại carbapenemase như KPC, NDM, VIM, IMP, OXA… với giới hạn phát hiện ấn tượng (10 CFU/mL) ngay cả với các carbapenemase yếu như OXA-48, trong khi vẫn duy trì mức độ chọn lọc cao.
Mục đích sử dụng :
CHROMagar™ mSuperCARBA™ là một môi trường nuôi cấy chromogen chọn lọc và phân biệt, được sử dụng trong phát hiện định tính sự mang mầm bệnh Enterobacteria kháng carbapenem (CRE) ở đường tiêu hóa, bao gồm nhà sản xuất OXA-48, để hỗ trợ ngăn ngừa và kiểm soát CRE trong cơ sở y tế. Xét nghiệm được thực hiện bằng mẫu gạc trực tràng và phân từ bệnh nhân để sàng lọc tình trạng mang CRE. Kết quả có thể được diễn giải sau 18-24 giờ ủ hiếu khí ở 35-37 °C.
CHROMagar™ mSuperCARBA™ không nhằm chẩn đoán nhiễm CRE cũng như không hướng dẫn hay theo dõi điều trị cho các nhiễm trùng. Thiếu sự phát triển hoặc không có khuẩn lạc trên CHROMagar™ mSuperCARBA™ không loại trừ sự hiện diện của CRE. Cần phải thực hiện thêm định danh, kiểm tra độ nhạy và định kiểu dịch tễ trên các khuẩn lạc nghi ngờ.
Thành phần

Tài liệu kỹ thuật
Công bố khoa học
2025
Evaluation of Chromogenic Medium for the Detection and Isolation of Carbapenem-Resistant Organisms from Perirectal Swabs
📄 Publication2023
Dissemination of carbapenemase-producing Enterobacterales through wastewater and gulls at a wastewater treatment plant in Sweden
📄 Publication2023
Intraregional hospital outbreak of OXA-244-producing Escherichia coli ST38 in Norway, 2020
📄 Publication2022
Genomic landscape of blaGES-5- and blaGES-24-harboring Gram-negative bacteria from hospital wastewater: emergence of class 3 integron-associated blaGES-24 genes
📄 Publication2022
Multidrug resistant bacteria on air, inanimate surface and medical equipment in an intensive care unit in Lima, Peru
📄 Publication2022
Surveillance and Control Efforts for Carbapenemase-Producing Gram-Negatives at a High Burden Vietnam University Hospital (abstract)
📄 Publication2022
A European multicenter evaluation study to investigate the performance on commercially available selective agar plates for the detection of carbapenemase producing Enterobacteriaceae
📄 Publication2021
Evidence of widespread endemic populations of highly multidrug-resistant Klebsiella pneumoniae seen concurrently through the lens of two hospital intensive care units in Vietnam
📄 Publication2021
Performance evaluation of screening medium for carbapenemase-producing Enterobacterales
📄 Publication2021
A prospective multicentre surveillance study to investigate the risk associated with contaminated sinks in the intensive care unit
📄 Publication2020
A genomic epidemiology study of multidrug-resistant Escherichia coli, Klebsiella pneumoniae and Acinetobacter baumannii in two intensive care units in Hanoi, Vietnam
📄 Publication2020
Environmental Presence and Genetic Characteristics of Carbapenemase-Producing Enterobacteriaceae from Hospital Sewage and River water in the Philippines
📄 Publication2020
Oral colonisation by antimicrobial-resistant Gram negative bacteria among long-term care facility residents: prevalence, risk factors and molecular epidemiology
📄 Publication2019
CHROMagar ESBL / mSuperCARBA bi-plate medium for detection of ESBL and carbapenemase-producing Enterobacteriaceae from spiked tools
📄 Publication2019
Evaluation of CHROMagar mSuperCARBA as a phenotypic test for detection of carbapenemase producing organisms
📄 Publication2018
Utility of CHROMagar mSuperCARBA for surveillance cultures of carbapenemase-producing Enterobacteriaceae
📄 Publication2018
Validation of Colorex™ ESBL/mSuperCARBA™ bi-plate on WASP®/WASPLab® to screen for ESBL and CPE
📄 Publication2018
Utility of CHROMagar mSuperCARBA for surveillance cultures of carbapenemase-producing Enterobacteriaceae
📄 Publication2018
Evaluation of carbapenemase-producing Enterobacteriaceae screening using CHROMagar™ mSuperCARBA™
📄 Publication2017
Dépistage du portage digestif d`entérobactéries productrices de carbapénemases (EPC) dans l Algérois durant l année 2016
📄 Publication2017
Comparative evaluation of a new commercial media, the CHROMAgar™ mSuperCARBA™, for the detection of carbapenemase-producing Enterobacteriaceae
📄 Publication2017
Evaluation of a new commercial medium, the CHROMagar mSuperCARBA, for the detection of carbapenemase-producing Enterobacteriaceae
📄 Publication2017
Amélioration de la détection des entérobactéries productrices de carbapénémase (EPC)
📄 Publication2016
Evaluation of different media for introduction of a CPE screening program at a UK hospital.
📄 Publication2016
CHROMagar mSuperCarba screening followed by Rapidec Carba NP test for detection of carbapenemase producers in Enterobacteriaceae
📄 Publication2016
CHROMagar mSuperCARBA performance in carbapenem-resistant Enterobacteriaceae isolates characterized at molecular level and routine surveillance rectal swab specimens
📄 Publication2016
Evaluation of CHROMagar™mSuperCARBA™ for the detection of carbapenemase producing Gram-negative organisms
📄 Publication2016
CHROMagar SuperCarba, un nuevo medio cromogénico-selectivo para la detección de organismos productores de carbapenemasas (CPO)
📄 Publication

Xem thêm